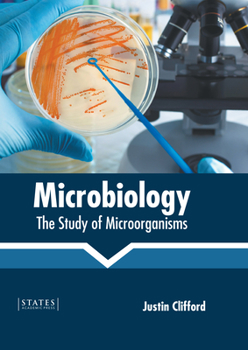
Hardcover Microbiology: The Study of Microorganisms Book

Microbiology: The Study of Microorganisms
The study of acellular, unicellular and multicellular microorganisms is known as microbiology. These microorganisms can be eukaryotic and prokaryotic. The various sub-fields of this discipline are mycology, virology, bacteriology, protozoology, phycology and parasitology. The integration of these fields leads to the formation of the field of microbiology. Microscopy, staining, identification based on DNA sequencing like the rDNA gene sequence are some of the techniques used in this field for the identification of microorganisms. This field of study is used for the treatment of cancer, digestion problems in humans, biodegrading industrial and agricultural wastes and for the production of multiple biopolymers such as polyesters and polyamides. This book elucidates the concepts and innovative models around prospective developments with respect to this field. It picks up individual branches and explains their need and contribution towards the development of microbiology. Coherent flow of topics, student friendly language and extensive use of examples make this an invaluable source of knowledge.
Format:Hardcover
Language:English
ISBN:1639893547
ISBN13:9781639893546
Release Date:September 2022
Publisher:States Academic Press
Length:245 Pages
Weight:1.42 lbs.
Dimensions:0.6" x 7.0" x 10.0"
Customer Reviews
0 rating